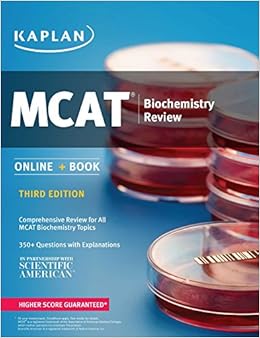

Free Downloads
MCAT Biochemistry Review: Online + Book (Kaplan Test Prep)

More people get into medical school with a Kaplan MCAT course than all major courses combined. Now the same results are available with MCAT Biochemistry Review. This book features thorough subject review, more questions than any competitor, and the highest-yield questions available. The commentary and instruction come directly from Kaplan MCAT experts and include targeted focus on the most-tested concepts.MCAT Biochemistry Review offers:UNPARALLELED MCAT KNOWLEDGE: The Kaplan MCAT team has spent years studying every MCAT-related document related available. In conjunction with our expert psychometricians, the Kaplan team is able to ensure the accuracy and realism of our practice materials.THOROUGH SUBJECT REVIEW: Written by top-rated, award-winning Kaplan instructors, all material has been vetted by editors with advanced science degrees and by a medical doctor.EXPANDED CONTENT THROUGHOUT: As the MCAT has continued to develop, this book has been updated continuously to match the AAMC’s guidelines precisely—no more worrying if your prep is comprehensive!“STAR RATINGS” FOR EVERY SUBJECT: New for the 3rd Edition of MCAT Biochemistry Review, every topic in every chapter is assigned a “star rating”—informed by Kaplan’s decades of MCAT experience and facts straight from the testmaker—of how important it will be to your score on the real exam.MORE PRACTICE THAN THE COMPETITION: With 350+ questions throughout the book and access to a full-length practice test online, MCAT Biochemistry Review has more practice than any other MCAT biochemistry book on the market.ONLINE COMPANION: One practice test and additional online resources help augment content studying. The MCAT is a computer-based test, so practicing in the same format as Test Day is key.TOP-QUALITY IMAGES: With full-color, 3-D illustrations, charts, graphs and diagrams from the pages of Scientific American, MCAT Biochemistry Review turns even the most intangible, complex science into easy-to-visualize concepts.KAPLAN'S MCAT REPUTATION: Kaplan is a leader in the MCAT prep market, and twice as many doctors prepared for the MCAT with Kaplan than with any other course.*UTILITY: Can be used alone or with the other companion books in Kaplan's MCAT Review series.* Doctors refers to US MDs who were licensed between 2001-2010 and used a fee-based course to prepare for the MCAT. The AlphaDetail, Inc. online study for Kaplan was conducted between Nov. 10 - Dec. 9, 2010 among 763 US licensed MDs, of whom 462 took the MCAT and used a fee-based course to prepare for it.

Series: Kaplan Test Prep
Paperback: 488 pages
Publisher: Kaplan Publishing; Third edition (July 5, 2016)
Language: English
ISBN-10: 1506203256
ISBN-13: 978-1506203256
Product Dimensions: 8.4 x 0.6 x 10.9 inches
Shipping Weight: 2 pounds (View shipping rates and policies)
Average Customer Review: 1.0 out of 5 stars See all reviews (1 customer review)
Best Sellers Rank: #107,278 in Books (See Top 100 in Books) #22 in Books > Education & Teaching > Higher & Continuing Education > Test Preparation > Graduate School > MCAT #101 in Books > Engineering & Transportation > Engineering > Bioengineering > Biochemistry #548 in Books > Education & Teaching > Studying & Workbooks > Study Guides
Not good for actually learning the stuff

Kaplan MCAT Biochemistry Review: Created for MCAT 2015 (Kaplan Test Prep) Kaplan MCAT Biochemistry Review: Book + Online (Kaplan Test Prep) Kaplan MCAT Complete 7-Book Subject Review: Created for MCAT 2015 (Kaplan Test Prep) MCAT Biochemistry Review: Online + Book (Kaplan Test Prep) Kaplan MCAT General Chemistry Review: Created for MCAT 2015 (Kaplan Test Prep) Kaplan MCAT Complete 7-Book Subject Review: Book + Online (Kaplan Test Prep) Kaplan MCAT Biology Review: Book + Online (Kaplan Test Prep) Kaplan MCAT Behavioral Sciences Review: Book + Online (Kaplan Test Prep) Kaplan MCAT Review Complete 5-Book Subject Review (Kaplan Test Prep) Sterling Test Prep MCAT Organic Chemistry & Biochemistry Practice Questions: High Yield MCAT Questions MCAT Biology and Biochemistry Review: New for MCAT 2015 (Graduate School Test Preparation) Kaplan MCAT 528: Advanced Prep for Advanced Students (Kaplan Test Prep) Kaplan GED Test 2016 Strategies, Practice, and Review: Online + Book (Kaplan Test Prep) MCAT Complete 7-Book Subject Review: Online + Book (Kaplan Test Prep) MCAT Behavioral Sciences Review: Online + Book (Kaplan Test Prep) MCAT Critical Analysis and Reasoning Skills Review: Online + Book (Kaplan Test Prep) MCAT Physics and Math Review: Online + Book (Kaplan Test Prep) MCAT Biology and Biochemistry: Content Review for the Revised MCAT Kaplan GMAT 2016 Strategies, Practice, and Review with 2 Practice Tests: Book + Online (Kaplan Test Prep) Kaplan ASVAB 2016 Strategies, Practice, and Review with 4 Practice Tests: Book + Online (Kaplan Test Prep)
